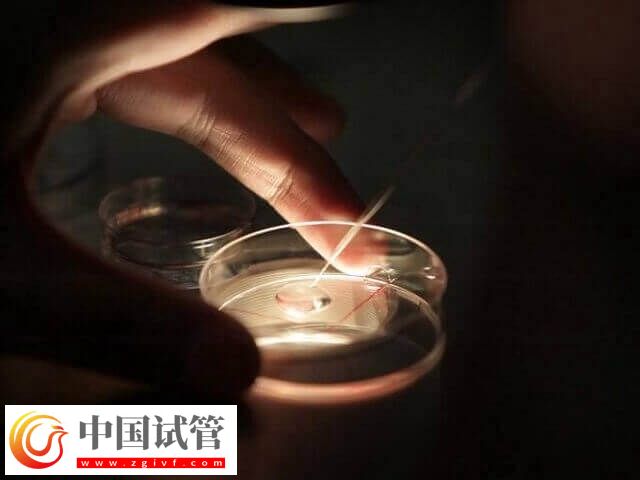
高龄是不是适合养囊胚(图2)

虽然做试管婴儿养囊的好处有很多,最明显的就是胚胎养囊成功之后再移植的妊娠成功的概率会比鲜胚大。但是做试管婴儿并不是所有人都适合养囊的。如果自身胚胎数量本身就不足,就不建议养囊了。特别是对于多囊、高龄、卵巢早衰的患者来说,其本身可用的卵泡就非常少,可能只有1-2个胚胎,这个时候选择养囊很可能会面临无胚可用。

养囊的好处
临床上认为女性在获得四个优胚后才会建议养囊,这是对胚胎质量和发育潜力的考察,本身养囊失败率就高,所以为了尽可能的规避风险,优胚的数量越多越好。
养囊最大的好处就是试管妊娠率高,在移植后不易失败,当然具体还不止这一点。临床上发现试验室培养到第3天的胚胎多为八细胞,七细胞,这叫鲜胚,而培养至5天以天则成了囊胚,这类胚胎已经发育成熟,在移植过程中对于内膜伤害最小。
- 在养囊的过程中会有一些携带异常染色体和基因的胚胎会因自身发育受限而淘汰,这就意味着留下的都是比较优质,且发育潜能较好的囊胚;
- 移植手术后,会以囊胚的形式进入到女性的子宫内,而囊胚是已经发育成熟的胚胎,所以着床后发育会更快,更稳定,不易出现着床后位置变动的情况;
- 囊胚在移植入子宫后,因为它的发育更接近于着床期,这就意味着缩短了宫腔内游离的时间,从而降低到达输卵管的几率,因此在一定程度上能够预防宫外孕的发生;
- 由于囊胚的着床率较高,所以一般是建议高龄女性移植单囊,这样才能有效避免双胎及多胎的发生率,但如果女性本身打算生双胎,可以在子宫容积达标的情况下选择双囊移植。
囊胚是一种已经发育成熟的胚胎,它的质量会更好,在做移植时对于女性子宫内膜的要求比较低,且移植后很容易就能成功着床,因此对于绝大多数高龄女性而言,囊胚移植是可以考虑的。
高龄女性做试管能否进行养囊
高龄做试管婴儿是可以养囊的,但是并不是所有人都适合。虽然囊胚在体外培养时间较长,是对早期胚胎的进一步筛选,发育潜能更大。但囊胚培养过程中会损耗掉一些胚胎质量差或者不适合体外培养环境的胚胎,尤其在女方高龄且胚胎数少的情况下,不适合囊胚培养。

每一种移植方式都有各自的优势,由于每个人情况不一样,所适合移植的胚胎也会有所差异,要结合自身情况,听从医生的专业建议。





